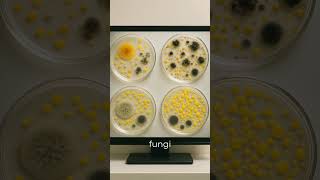

Shared 2 years ago
12K views
Shared 1 year ago
4.8K views
Shared 1 year ago
1.5M views
Shared 4 years ago
20K views
Shared 1 year ago
11K views
Shared 1 year ago
85K views
Shared 2 years ago
1.3K views
Shared 8 months ago
6.6K views
Shared 1 year ago
51K views
Blood total protein measurement tutorial #clinicalskills #veterinary #medicine #medschool #bloodtest
Shared 2 years ago
423K views
Shared 7 months ago
14K views
Shared 2 years ago
75K views
Shared 8 months ago
1.4K views
Shared 1 year ago
78K views
Shared 2 years ago
120K views
Shared 3 years ago
86K views
Shared 5 months ago
81K views
Shared 3 years ago
794K views
Shared 10 months ago
767 views
Shared 7 months ago
21K views
Shared 8 months ago
155 views
Shared 1 year ago
3.9K views
Shared 9 months ago
1.6K views
Shared 2 years ago
276K views
Shared 3 years ago
28K views
Shared 7 months ago
1M views
Shared 3 years ago
25K views